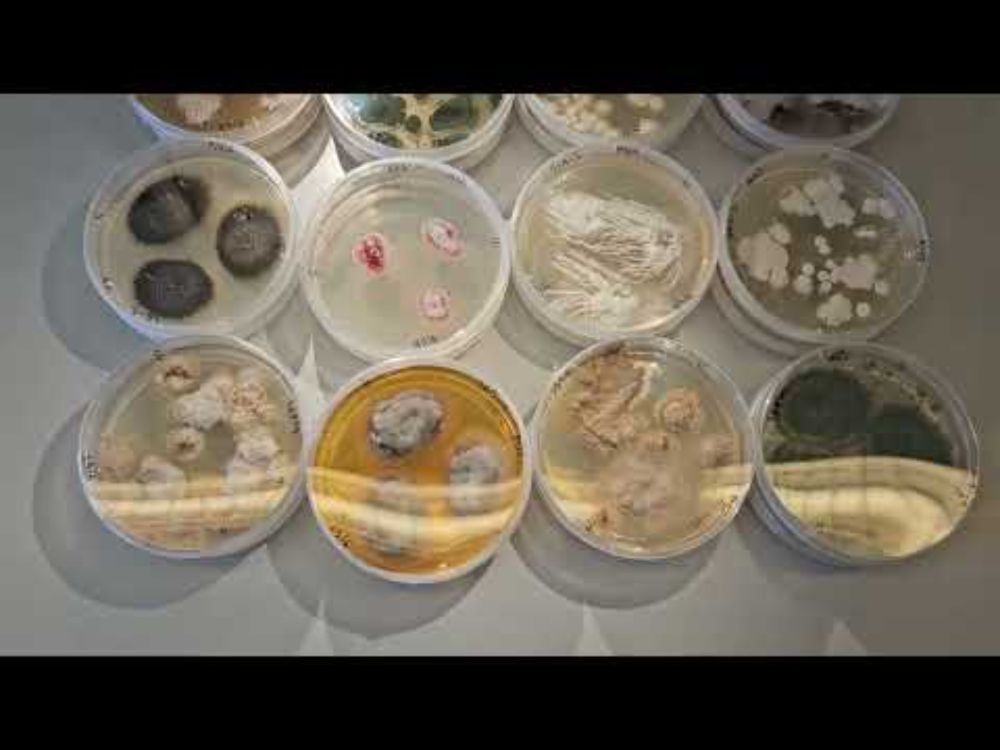

🇨🇴 Guajira | UniAndes MSc Environmental microbiology BSc MBIO BSc BIO | 🇬🇧 UEA PhD Microbial ecology 🌱🦠 DNA-SIP
Former #IB school #MYP coordinator 👩🏽🏫
Crafty 🧶 | Mamá & wife | Views my own
www.nasmillelarkemejia.com
nasmillelarkemejia.com









www.youtube.com/watch?v=BEzo...
www.youtube.com/watch?v=BEzo...




VOLT is looking PhD students for 2 exciting projects, please apply or share with your network!
#PhD fellowship in #microbial #Volatile Organic Compound exchange in #Arctic #glacier #ecosystems: employment.ku.dk/phd/?show=16...

VOLT is looking PhD students for 2 exciting projects, please apply or share with your network!
#PhD fellowship in #microbial #Volatile Organic Compound exchange in #Arctic #glacier #ecosystems: employment.ku.dk/phd/?show=16...



Visitors got to hear a talk on hidden #fungaldiversity in #caves, and explored a collaborative booth. Here they could peek at fungal cultures under a microscope🔬, watch a short film highlighting the research, and learn about cave fungi and #VOCs.
Visitors got to hear a talk on hidden #fungaldiversity in #caves, and explored a collaborative booth. Here they could peek at fungal cultures under a microscope🔬, watch a short film highlighting the research, and learn about cave fungi and #VOCs.
Reflections on my first year as a Marie Skłodowska-Curie Fellow in Denmark — the science, the challenges, and the journey toward independence. 🌱
nasmillelarkemejia.com/one-year-as-...
#uArctic_project

Reflections on my first year as a Marie Skłodowska-Curie Fellow in Denmark — the science, the challenges, and the journey toward independence. 🌱
nasmillelarkemejia.com/one-year-as-...
#uArctic_project
shorturl.at/22mEG

shorturl.at/22mEG
“Dr Goodall’s discoveries as an ethologist revolutionised science,” the statement read. “She was a tireless advocate for the protection and restoration of our natural world.”

“Dr Goodall’s discoveries as an ethologist revolutionised science,” the statement read. “She was a tireless advocate for the protection and restoration of our natural world.”
@voltcenter.bsky.social's postdoc Cecilia Costas Selas and PhD student Eve Galen are attending the #SAME18 #aquatic #microbes #conference.
Enjoy the sunshine and the talks, posters and discussions!

@voltcenter.bsky.social's postdoc Cecilia Costas Selas and PhD student Eve Galen are attending the #SAME18 #aquatic #microbes #conference.
Enjoy the sunshine and the talks, posters and discussions!














